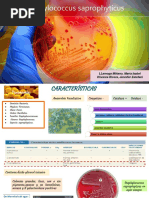

0% encontró este documento útil (1 voto)
778 vistas4 páginasStaphylococcus Saprophyticus
Staphylococcus saprophyticus es un microorganismo que habita el tracto gastrointestinal humano y puede causar infecciones urinarias. Sus principales factores de virulencia son la adherencia a células uroepiteliales mediante proteínas de superficie como Ssp y una hemaglutinina, así como la producción de ureasa y matriz extracelular que le permiten formar biopelículas y causar infecciones recurrentes.
Cargado por
Maria Isabel Llamoga MiñanoDerechos de autor
© © All Rights Reserved
Nos tomamos en serio los derechos de los contenidos. Si sospechas que se trata de tu contenido, reclámalo aquí.
Formatos disponibles
Descarga como PPTX, PDF, TXT o lee en línea desde Scribd
0% encontró este documento útil (1 voto)
778 vistas4 páginasStaphylococcus Saprophyticus
Staphylococcus saprophyticus es un microorganismo que habita el tracto gastrointestinal humano y puede causar infecciones urinarias. Sus principales factores de virulencia son la adherencia a células uroepiteliales mediante proteínas de superficie como Ssp y una hemaglutinina, así como la producción de ureasa y matriz extracelular que le permiten formar biopelículas y causar infecciones recurrentes.
Cargado por
Maria Isabel Llamoga MiñanoDerechos de autor
© © All Rights Reserved
Nos tomamos en serio los derechos de los contenidos. Si sospechas que se trata de tu contenido, reclámalo aquí.
Formatos disponibles
Descarga como PPTX, PDF, TXT o lee en línea desde Scribd